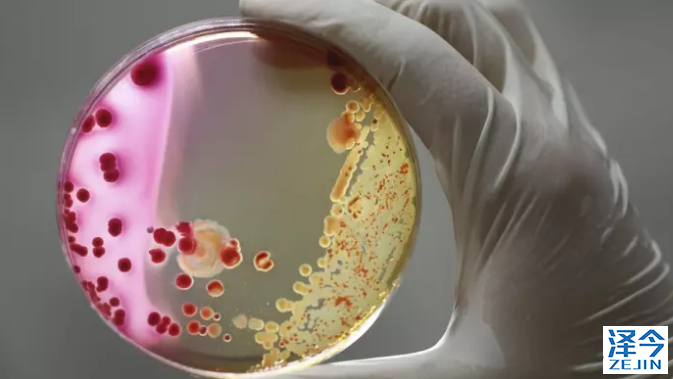
【AstraZeneca】阿斯利康制药公司快速跟踪Tagrisso辅助诊断

制药公司接受较低的销售,因为他们转向个性化治疗。
美国监管机构上个月向阿斯利康公司提供了一个新的肺癌治疗绿灯,标志着创纪录的最快的药物批准之一。 这个过程有时可能需要十年或更长时间,但是公司花了两年半的时间才在第一次人体试验后才能进入市场。
速度快的原因之一是药物Tagrisso的高度针对性的性质。它的目标是肺癌患者的一个子集,其肿瘤已经扩散并发展了治疗抗性突变。这意味着试验发生在相对较小和明确定义的患者组中。
这是药物公司从一次性药物转向更为个性化药物的加速转变的最新例证。支持这种趋势的是“伴随诊断”的兴起,其确定了受益的患者。
对于制药行业来说,个性化医疗的兴起意味着接受比传统大片所获得的更低的销售量。但它承诺加速发展,帮助展示新产品的价值,当时药品价格正受到来自世界各地预算有限的卫生系统的严格监管。
英国阿斯利康公司肿瘤业务负责人Greg Rossi说:“我们可以提供更好的价值主张,如果我们可以确定谁会受益和删除那些不会的患者。”
Tagrisso针对具有称为EGFR和T790M的两种遗传突变的非小细胞肺癌患者(NSCLC)。约10%的NSCLC患者表现出EGFR,其中三分之二是T790M阳性。 AstraZeneca制药公司与瑞士制药集团Roche的诊断部门合作,开发了突变基因的测试。
泰瑞沙AZD9291常见问题
【1】孟加拉泰瑞沙AZD9291使用说明书
【2】吴一龙教授解惑:关于泰瑞沙(AZD9291)
【3】易瑞沙官方验证(免费),助患者远离假药
【4】泰瑞沙AZD9291上市到被批准为一线治疗的过程
【5】靶向药用药规则被打破——泰瑞沙azd9291升级一线治疗
【6】肺癌靶向药克唑替尼、奥希替尼AZD9291有仿制药吗
【7】孟加拉BEACON厂家生产的泰瑞沙AZD9291官方售价多少
【8】阿斯利康第三代肺癌靶向药物泰瑞沙在中国获批
【9】泰瑞沙(AZD9291)适合服用的人群有哪些
【10】泰瑞莎——孟加拉碧康黑盒版
【11】认识肺癌
【12】肺癌完胜化疗,泰瑞沙治疗肺癌脑转移缓解率高达70%